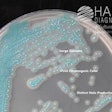

Hardy Diagnostics Compact Dry bacterial detection is a method for cultivating and counting common foodborne microorganisms. Compact Dry is a self-contained device containing a membrane matrix saturated with a culture medium and a gelling agent, and then dried. A diluted food sample (1mL) is added to the center of the device, is then incubated, and a technician counts the colonies. Compact Dry is available in many formats and can detect many different types of microorganisms.